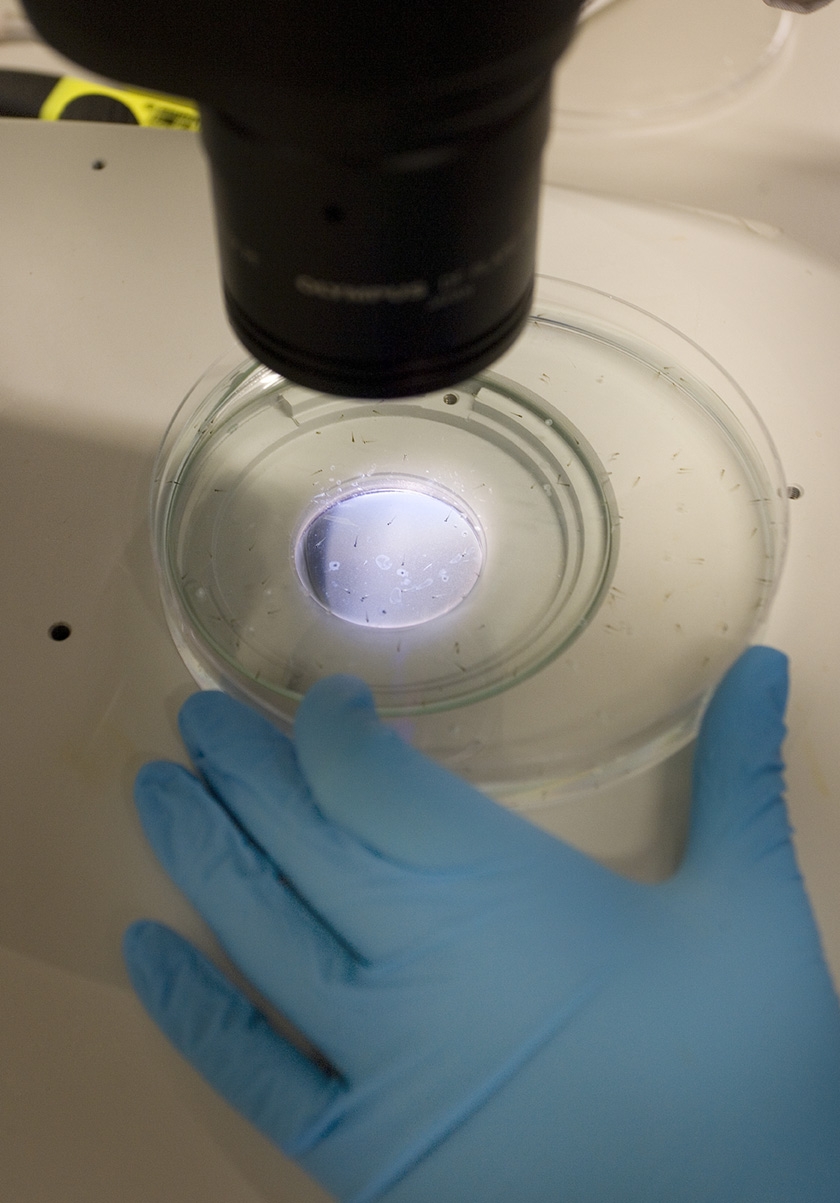
Biobide laboratory

GLP-compliant aquatic ecotoxicology studies conducted under OECD guidelines — delivering robust, submission-ready data for REACH, biocides, agrochemicals, and chemical registrations worldwide.


In an increasingly demanding regulatory landscape, assessing the environmental impact of chemical substances and plant protection products is a critical step in securing market approval.
Biobide, a Biat Group subsidiary, delivers GLP-certified aquatic ecotoxicology testing backed by experienced scientific teams — with flexible study designs even for challenging substances.

From regulatory alignment to a final submission-ready report — one integrated workflow that minimises delays and maximises data reliability.

Zebrafish embryos at 48 hours post-fertilisation — a key endpoint in OECD 236 FET studies, providing sensitive, ethically advanced vertebrate toxicity data.
Whether you need a single OECD study or a full testing program, Biobide — a Biat Group company — helps you generate regulatory-ready ecotoxicology data on time and with confidence.
| Cookie | Duration | Description |
|---|---|---|
| cookielawinfo-checkbox-analytics | 11 months | This cookie is set by GDPR Cookie Consent plugin. The cookie is used to store the user consent for the cookies in the category "Analytics". |
| cookielawinfo-checkbox-functional | 11 months | The cookie is set by GDPR cookie consent to record the user consent for the cookies in the category "Functional". |
| cookielawinfo-checkbox-necessary | 11 months | This cookie is set by GDPR Cookie Consent plugin. The cookies is used to store the user consent for the cookies in the category "Necessary". |
| cookielawinfo-checkbox-others | 11 months | This cookie is set by GDPR Cookie Consent plugin. The cookie is used to store the user consent for the cookies in the category "Other. |
| cookielawinfo-checkbox-performance | 11 months | This cookie is set by GDPR Cookie Consent plugin. The cookie is used to store the user consent for the cookies in the category "Performance". |
| viewed_cookie_policy | 11 months | The cookie is set by the GDPR Cookie Consent plugin and is used to store whether or not user has consented to the use of cookies. It does not store any personal data. |
| Cookie | Duration | Description |
|---|---|---|
| _ga | 11 months | Cookie from Google Inc. to collect web statistics. No personal user data is collected. |
| _ga_******** | 11 months | Cookie from Google Inc. to collect web statistics. No personal user data is collected. |
| _gid | 11 months | Cookie from Google Inc. to collect web statistics. No personal user data is collected. |

